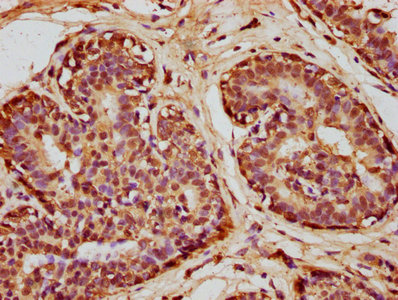

-
中文名稱:SOD1兔多克隆抗體
-
貨號:CSB-PA02864A0Rb
-
規格:¥440
-
圖片:
-
Western blot
All lanes: SOD1 antibody at 6µg/ml
Lane 1: Mouse liver tissue
Lane 2: Mouse brain tissue
Lane 3: Hela whole cell lysate
Lane 4: MCF-7 whole cell lysate
Lane 5: A549 whole cell lysate
Lane 6: HepG2 whole cell lysate
Secondary
Goat polyclonal to rabbit IgG at 1/10000 dilution
Predicted band size: 16 kDa
Observed band size: 16 kDa -
IHC image of CSB-PA02864A0Rb diluted at 1:100 and staining in paraffin-embedded human breast cancer performed on a Leica BondTM system. After dewaxing and hydration, antigen retrieval was mediated by high pressure in a citrate buffer (pH 6.0). Section was blocked with 10% normal goat serum 30min at RT. Then primary antibody (1% BSA) was incubated at 4°C overnight. The primary is detected by a biotinylated secondary antibody and visualized using an HRP conjugated SP system.
-
Immunofluorescent analysis of 293T cells using CSB-PA02864A0Rb at dilution of 1:100 and Alexa Fluor 488-congugated AffiniPure Goat Anti-Rabbit IgG(H+L)
-
-
其他:
產品詳情
-
產品名稱:Rabbit anti-Homo sapiens (Human) SOD1 Polyclonal antibody
-
Uniprot No.:
-
基因名:
-
別名:ALS antibody; ALS1 antibody; Amyotrophic lateral sclerosis 1 adult antibody; Cu/Zn SOD antibody; Cu/Zn superoxide dismutase antibody; Epididymis secretory protein Li 44 antibody; HEL S 44 antibody; Homodimer antibody; hSod1 antibody; Indophenoloxidase A antibody; IPOA antibody; Mn superoxide dismutase antibody; SOD antibody; SOD soluble antibody; SOD1 antibody; SOD2 antibody; SODC antibody; SODC_HUMAN antibody; Superoxide dismutase [Cu-Zn] antibody; Superoxide dismutase 1 antibody; Superoxide dismutase 1 soluble antibody; Superoxide dismutase Cu Zn antibody; Superoxide dismutase cystolic antibody
-
宿主:Rabbit
-
反應種屬:Human, Mouse
-
免疫原:Recombinant Human Superoxide dismutase [Cu-Zn] protein (2-154AA)
-
免疫原種屬:Homo sapiens (Human)
-
標記方式:Non-conjugated
本頁面中的產品,SOD1 Antibody (CSB-PA02864A0Rb),的標記方式是Non-conjugated。對于SOD1 Antibody,我們還提供其他標記。見下表:
-
克隆類型:Polyclonal
-
抗體亞型:IgG
-
純化方式:>95%, Protein G purified
-
濃度:It differs from different batches. Please contact us to confirm it.
-
保存緩沖液:Preservative: 0.03% Proclin 300
Constituents: 50% Glycerol, 0.01M PBS, PH 7.4 -
產品提供形式:Liquid
-
應用范圍:ELISA, WB, IHC, IF
-
推薦稀釋比:
Application Recommended Dilution WB 1:1000-1:5000 IHC 1:20-1:200 IF 1:50-1:200 -
Protocols:
-
儲存條件:Upon receipt, store at -20°C or -80°C. Avoid repeated freeze.
-
貨期:Basically, we can dispatch the products out in 1-3 working days after receiving your orders. Delivery time maybe differs from different purchasing way or location, please kindly consult your local distributors for specific delivery time.
-
用途:For Research Use Only. Not for use in diagnostic or therapeutic procedures.
引用文獻
- Liposome-based Freezing Medium Improves the Outcome of Mouse Prepubertal Testicular Tissue Cryopreservation R Dcunha, SP Mutalik, RA Reji, S Mutalik,Reproductive Sciences,2024
- Dietary supplementation of grape seed tannin extract stimulated testis development, changed fatty acid profiles and increased testis antioxidant capacity in pre-puberty hu lambs Wanhong Li,Theriogenology,2021
相關產品
靶點詳情
-
功能:Destroys radicals which are normally produced within the cells and which are toxic to biological systems.
-
基因功能參考文獻:
- These results show that secosterol aldehydes are increased in plasma of symptomatic amyotrophic lateral sclerosis rats, overexpressing multiple copies (~8 copies) of G93A mutant human SOD1, and represent a class of aldehydes that can potentially modify SOD1 enhancing its propensity to aggregate. PMID: 30142602
- Study results in transgenic mice carrying human SOD1 gene and analysis of cerebrospinal fluid as well as the spinal cord homogenate amyotrophic lateral sclerosis (ALS) patients suggest that metal-deficiency in mutant SOD1 at its copper-binding site is one of the earliest pathological features in SOD1-ALS. PMID: 29551730
- A stable core of the SOD2 that unfolds last and refolds first, and directly observe several distinct misfolded states that branch off from the native folding pathways at specific points after the formation of the stable core. PMID: 29192167
- The relevance of contact-independent cell-to-cell transfer of TDP-43 and SOD1 in amyotrophic lateral sclerosis. PMID: 28711596
- the introduction of SOD1(G93A) and TDP43(A315T), established Amyotrophic lateral sclerosis (ALS)-related mutations, changed the subcellular expression and localization of RNAs within the neurons, showing a spatial specificity to either the soma or the axon. Altogether, we provide here the first combined inclusive profile of mRNA and miRNA expression in two ALS models at the subcellular level. PMID: 28300211
- Shorter activated partial thromboplastin time and increased SOD levels might be useful hemostatic markers in patients with type 2 diabetes mellitus. PMID: 30143488
- In this study we demonstrate dynamic changes in the number of calretinin- (CR) and neuropeptide Y-expressing (NPY) interneurons in the motor cortex of the familial hSOD1(G93A) ALS mouse model, suggesting their potential involvement in motor neuron circuitry defects PMID: 28294153
- Our results suggest that SOD1 mutation is the most common cause of amyotrophic lateral sclerosis(ALS) in Chinese populations and that the mutation spectrum of ALS varies among different ethnic populations PMID: 28291249
- Weak significance was observed for a protective effect of the TT genotype of rs1041740 in the SOD1 gene relative to Type 1 Diabetes development (OR 0.318, 95% CI 0.092-0.959, p = 0.056). PMID: 29924645
- SOD1 is S-acetylated in spinal cord homogenates from ALS and non-ALS subjects. The degree of S-acylation is highest for SOD1-CCS heterodimers and lowest for SOD1 monomers. PMID: 28120938
- Study suggests that endoplasmic reticulum stress increases the susceptibility of SOD1WT to aggregate during aging, operating as a possible risk factor for developing amyotrophic lateral sclerosis. PMID: 30038021
- Metallation and oxidation of SOD1 stabilize the native, mature conformation and decrease the number of detected excited conformational states. PMID: 29483249
- results thus shed light on the role of local unfolding and conformational dynamics in aggregation of SOD1 PMID: 29369331
- Certain SOD1 mutants, viz. His80Arg and Asp83Gly, were recognized that were more damaging to the Zn binding loop than all other mutants, leading to a loss of Zn binding with altered coordination of the Zn ion. Furthermore, the conformational stability, compactness, and secondary structural alteration of the His80Arg and Asp83Gly mutants were monitored using distinct parameters. PMID: 28271284
- describe here two cases of apparently sporadic amyotrophic lateral sclerosis associated with mutations, respectively, in SOD1 and TARDP genes PMID: 27494151
- that global changes in DNA methylation might contribute to the ALS phenotype in carriers of not fully penetrant SOD1 mutations PMID: 28859526
- The present study indicating that although the Ins/Del polymorphism of SOD1 is associated with the SOD1 expression levels, this polymorphism is not associated with the risk of dependency to heroin. PMID: 29165112
- The mutant human SOD1-G93A protein induced axonal and myelin degeneration during the progression of Amyotrophic Lateral Sclerosis in a mouse model and participated in axon remyelination and regeneration in response to injury. PMID: 29742495
- SOD1 oligomer and not the mature form of aggregated fibril is critical for the neurotoxic effects in the model of amyotrophic lateral sclerosis. PMID: 29666246
- Data suggest that serum SOD1 levels are decreased in patients with controlled or uncontrolled acromegaly as compared to healthy subjects; in acromegaly, SOD1 levels are not associated with MnSOD/SOD2 polymorphisms. PMID: 29046499
- Ovariectomy resulted in earlier disease onset and attenuated the anti-inflammatory and anti-apoptotic actions of estrogen in hSOD1-G93A transgenic mice. PMID: 29394243
- a measure of hydrogen bond stability in conformational states was studied with elastic network analysis of 35 SOD1 mutants. PMID: 29431095
- The genetic mutations of SOD1 caused amyotrophic lateral sclerosis PMID: 29478603
- the study provides a better understanding over the profound effect of mutation on SOD1, both structurally and functionally, using computational approaches. PMID: 28899654
- SOD1 amino acid residues forming these pathogenic hydrogen bonds are found in zinc-binding and electrostatic loops as well as at zinc-binding sites and are in contact with SOD1 aggregates, which implies that these regions are sensitive to perturbations from pathogenic mutations. PMID: 28950184
- show a clear variation of the different SOD1 mutants to associate with mitochondrial-enriched fractions with a correlation between mutation severity and this association PMID: 28715630
- Study shows that in senile cataracts, SOD1 expression decreased significantly. Both H3 and H4 were deacetylated at -600 bp of the SOD1 promoter of cataract lenses, and hypoacetylated at -1500, -1200, and -900 bp. In hypoacetylated histones, the hypoacetylation pattern differed among the cataracts sub-types. Further functional data provide evidence that histone acetylation plays an essential role in the regulation of SOD1. PMID: 27703255
- Study shows that SOD1 forms fibrillar aggregates under quiescent conditions at near-physiological pH, ionic strength, and temperature over a time frame of weeks; and that intermolecular disulfide bonds are not required for the protein to form aggregates, even in the absence of fibril seeds. Scrambling of intramolecular disulfide bonds is not required for aggregation. Urea denaturation increases aggregation lag time. PMID: 28585802
- SOD1 G93A mutant from familial amyotrophic lateral sclerosis cases binds VDAC1 with high affinity. PMID: 27721436
- Like other neurodegenerative diseases, misfolding of a specific protein is central to ALS. SOD1, the major constituent of the protein deposits in some familial and sporadic forms of ALS, propagates its misfolded conformation like prions, providing a plausible molecular basis for the focality and spreading of muscle weakness in ALS PMID: 28096265
- Data show that cholecystectomy patients with enhanced levels of superoxide dismutase (SOD1) appeared to have significantly lower number of analgesic oxycodone doses during the first 24 h postoperatively (NAD24). PMID: 29848712
- the structural changes and the alteration in distance between Zn and its binding residues which cause the loss of Zn binding was studied in details to delivery the foresight on the impact of the mutation in SOD1. PMID: 27555441
- antioxidant activity of erythrocyte SOD is associated with dementia severity. PMID: 28965606
- Results provide evidence that ALS mutant SOD1 inhibits axonal transport of mitochondria by inducing PINK1/Parkin-dependent Miro1 degradation. PMID: 28973175
- Study reveals presence of glial cell proliferation in both motor (brainstem) and non-motor (hippocampus) CNS structures of hSOD1G93A ALS rats starting already at the presymptomatic stage of the disease. A specific timeline of glial response is demonstrated in the brainstem of these animals with the activation of astrocytes coming first and before disease onset, followed by activation of microglia in the symptomatic phase. PMID: 28576725
- SOD1 mutations were present in 20% of familial amyotrophic lateral sclerosis (ALS) patients and 1.9% of sporadic ALS patients, while FUS mutations were responsible for 13.3% of familial ALS cases, and TARDBP mutations were rare in either familial or sporadic ALS cases. PMID: 27604643
- Significant association between the SOD1 Ins/Del polymorphism and age of onset in bipolar disorder type 1. PMID: 28750571
- Data provide evidence that metal binding, in addition of being necessary for SOD1 enzymatic activity, is a key factor in the aggregation process of SOD1. In particular, both demetalation and aberrant metal binding have been shown to promote misfolding and aggregation in SOD1 suggesting a possible role of metal binding in SOD1 pathological aggregation. [review] PMID: 28850080
- SOD1 heterodimerization rate is influenced by mutation and is correlated with survival times in amyotrophic lateral sclerosis. PMID: 27054659
- early stage influenza A virus infection induces autophagic degradation of antioxidant enzyme SOD1, thereby contributing to increased ROS generation and viral infectivity in alveolar epithelial cells. PMID: 29548827
- Computational investigation of the human SOD1 mutant, Cys146Arg, that directs familial amyotrophic lateral sclerosis, has been reported. PMID: 28621357
- Suggest a complex role of SOD1 in different processes leading to complications of liver cirrhosis. rs1041740 might be associated with the development of ascites and possibly plays a role in spontaneous bacterial peritonitis once ascites has developed. PMID: 28403123
- SOD1 gene polymorphisms associated with susceptibility to noise-induced hearing loss. PMID: 29072670
- all affected members, except the proband's father, who was unavailable for DNA analysis, showed a heterozygous mutation (c.125G>A) in exon 2 of the SOD1 gene. We found that the executive domain, attention domain, language function, calculation tasks and memory were significantly impaired in the patients with ALS compared to the healthy family members. PMID: 26069299
- Slowly upper and lower motor neuron degeneration, even with non-motor clinical features, should prompt a sequencing of SOD1 PMID: 27892702
- research demonstrated that erysipelas infection predisposition and its clinical characteristics are affected by age, sex and SNPs found in SOD1, SOD2, and catalase genes; presence of SOD1 G7958 alleles was linked to erysipelas' predisposition; G and A alleles of SOD1 G7958A individually were associated with lower limbs and higher body part localizations of the infection, respectively PMID: 28512644
- Low SOD1 Expression Is Associated with Postoperative Pain. PMID: 29374733
- Our data indicate that SOD1 is directly or indirectly involved in ALS oligodendrocyte pathology and suggest that in this cell type, some damage might be irreversible. PMID: 27688759
- Gelsolin enhances the invasive capacity of colon cancer cells via elevating intracellular superoxide (O2.-) levels by interacting with Cu/ZnSOD, and gelsolin gene expression positively correlates with urokinase plasminogen activator (uPA), an important matrix-degrading protease invovled in cancer invasion. PMID: 27391159
- The observation that beta-strand 5 is among the first to unfold here, but the last to unfold in simulations of loop-truncated SOD1, could imply the existence of an evolutionary compensation mechanism, which would stabilize beta-strands flanking long loops against their entropic penalty by strengthening intramolecular interactions. PMID: 28629863
顯示更多
收起更多
-
相關疾病:Amyotrophic lateral sclerosis 1 (ALS1)
-
亞細胞定位:Cytoplasm. Mitochondrion. Nucleus.
-
蛋白家族:Cu-Zn superoxide dismutase family
-
數據庫鏈接:
Most popular with customers
-
-
YWHAB Recombinant Monoclonal Antibody
Applications: ELISA, WB, IHC, IF, FC
Species Reactivity: Human, Mouse, Rat
-
-
-
-
-
-
VDAC1 Recombinant Monoclonal Antibody
Applications: ELISA, WB, IHC
Species Reactivity: Human, Mouse, Rat